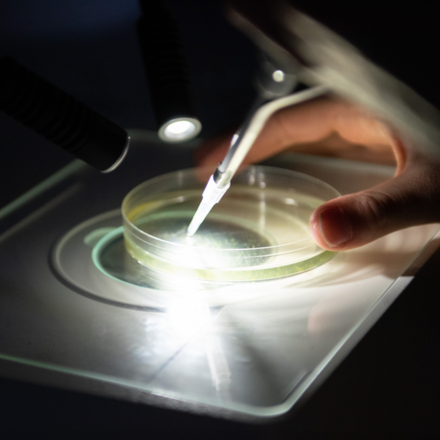

O nás
Přírodovědecká fakulta ústecké univerzity je moderní vysokoškolskou institucí, zároveň největší v ústeckém regionu zaměřenou na vzdělávání a rozvoj poznání v oblasti přírodních oborů. Kromě více než šedesátileté tradice nabízí netradiční zázemí v podobě přírodních krás severních Čech (údolí Labe, Národní park České Švýcarsko a České středohoří). Doménou zdejší univerzity je takřka rodinné prostředí a individuální přístup ke studentům.
Fakulta zajišťuje vysokoškolské vzdělání všech tří stupňů (Bc., Mgr., Ph.D.) pro odborníky v přírodovědných oborech, včetně přípravy učitelů pro 2. stupeň základních škol a pro střední školy v přírodovědných předmětech. Spolupracuje s řadou českých i zahraničních partnerů, včetně soukromého sektoru.
Studijní programy
Fakulta nabízí širokou škálu oborů, počínaje biologií a fyzikou přes geografii a informační technologie po matematiku a chemii, v prezenční či kombinované formě studia. Mezi mladé obory vyučované na fakultě patří Aplikované nanotechnologie, Matematika ve firmách a veřejné správě, Biologie – specializace Experimentální a buněčná biologie a Počítačové modelování ve vědě a technice.
Uplatnění
Absolventi nacházejí uplatnění v institucích veřejné správy, orgánech a institucích Evropské unie, ochrany přírody, krajinném plánování, laboratořích, výzkumných ústavech, dále v cestovním ruchu, jako správci sítí či programátoři, vývojáři webových aplikací, a to jak ve státní, tak soukromé sféře. V neposlední řadě se uplatní jako učitelé přírodovědných předmětů na základních a středních školách.
Kde nás najdeš
Přírodovědecká fakulta
Univerzita Jana Evangelisty Purkyně v Ústí nad Labem
Pasteurova 3632/15
400 96 Ústí nad Labem
Přihlášky a přijímačky
Do jednooborových studijních programů Aplikovaná informatika, Aplikované nanotechnologie, Geografie, Aplikovaná chemie, Matematika ve firmách a veřejné správě a Počítačové modelování ve vědě a technice jsou uchazeči přijímáni bez přijímací zkoušky.
Do jednooborového studijního programu Biologie jsou uchazeči přijímáni na základě písemného testu.
Do dvouoborových studijních programů Fyzika, Geografie, Chemie, Informatika a Matematika jsou uchazeči přijímáni bez přijímací zkoušky.
Do dvouoborového studijního programu Biologie jsou uchazeči přijímáni na základě písemného testu.
Navazující magisterské studijní obory
Do studijních programů Učitelství biologie pro SŠ a Učitelství geografie pro SŠ jsou uchazeči přijímáni bez přijímací zkoušky. Do jednooborového studijního programu Geografie jsou uchazeči přijímáni na základě strukturovaného portfolia. Do ostatních studijních programů jsou uchazeči přijímáni na základě ústního pohovoru, který může být při splnění určitých podmínek prominut.
- Elektronická přihláška: 800 Kč
Aktuality
Doplňující informace
Studium v zahraničí
Fakulta nabízí studium v zahraničí především v rámci programu Erasmus+. Bližší informace o studiu v zahraničí naleznete zde.
Stáže v zahraničí
Pomocí programu Erasmus+ je možné vycestovat do zahraničí i na pracovní stáž. Studenti Přírodovědecké fakulty mají možnost zapojit se do výzkumných týmů, procházet praxí u partnerských společností a získat tím větší šance pro budoucí uplatnění na trhu práce.
Ubytování a koleje
Univerzita Jana Evangelisty Purkyně nabízí v Ústí nad Labem bydlení na 4 kolejích. Pravidla pro ubytování, druhy ubytování a jejich ceník naleznete na webových stránkách Správy kolejí a menz UJEP zde. Další možností je ubytování privátní. Obvykle jsou nabídky na privátní ubytování vyvěšeny na nástěnkách ve vestibulech jednotlivých částí univerzity.
Kontakt
Přírodovědecká fakulta
Univerzita Jana Evangelisty Purkyně v Ústí nad Labem
Pasteurova 3632/15
400 96 Ústí nad Labem